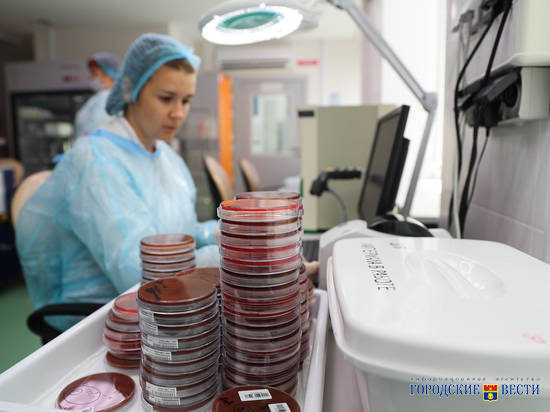
Современный лабораторный центр появится в Михайловском районе Волгоградской области

Современный лабораторный центр появится в Михайловском районе Волгоградской области
Об этом губернатор заявил во время рабочей поездки в поликлинику № 2.
Сегодня губернатор Волгоградской области побывал в клинико-диагностической лаборатории волгоградской поликлиники № 2.
- В 2015 году мы ставили задачу по созданию современного государственного лабораторно-диагностического центра в Волгоградской области. Сегодня завершены первый и второй этапы, - подчеркнул Андрей Бочаров. - В регионе создали новейший центр, который позволяет быстро и качественно проводить необходимые исследования и ставить диагнозы для эффективного лечения. Такой центр - единственный в ЮФО.
Всего за 2,5 года работы специалисты центра провели более 14 млн исследований. Важно, что все они бесплатны для граждан, их проводят по полису ОМС.
Во время совещания отметили, что необходимо открывать такие центры и в других городах региона, чтобы повысить доступность высокоточных оперативных исследований.
- Мы приступаем к реализации третьего этапа - расширению мощностей государственного лабораторно-диагностического центра. Один из таких комплексов создадут в Михайловке, он будет обслуживать северные районы области. В пяти поликлиниках Волгоградской области в рамках пилотного проекта откроют современные пункты забора крови, - подчеркнул Андрей Бочаров. - Также продолжается работа по оснащению лечебных учреждений оборудованием, чтобы проводить исследования в стационарах. Без качественных исследований невозможно говорить о развитии современной системы здравоохранения, поэтому мы сконцентрировали усилия на создании такого центра.
В рамках второго этапа создали новое подразделение консультативно-диагностической поликлиники № 2 - микробиологическая лаборатория и лаборатория ПЦР-диагностики работают в Краснооктябрьском районе. Здесь выполняют 45 видов микробиологических и 98 видов молекулярно-генетических исследований. Использование новейших технологий позволяет обнаруживать в биоматериале все виды бактерий, вирусов и грибов. Доступ к лабораторно-диагностической службе микробиологических исследований и ПЦР-диагностики получили все больницы и поликлиники региона.
Напомним, первый этап создания единого государственного лабораторно-диагностического центра завершили в начале 2016 года. Проект реализовали менее чем за год на условиях государственно- частного партнерства. Лабораторно-диагностический центр на базе поликлиники № 2 выполняет 93 вида исследований. Оборудование центра рассчитано на обработку 12 тысяч пробирок в день. В 2017 году ввели метод исследования по разделу "биохимия", что позволило повысить качество диагностики по раннему выявлению онкопатологии.


















